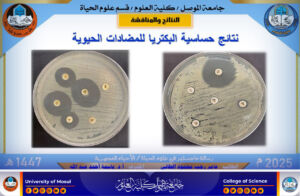
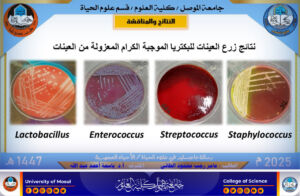
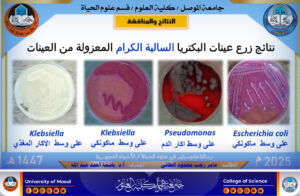
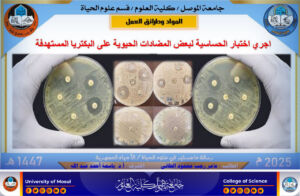

14 سبتمبر، 2025
رسالة ماجستير تكشف عن أول تسجيل لبكتريا Facklamia hominis في العراق

ناقش قسم علوم الحياة في كلية العلوم بجامعة الموصل، يوم الأحد الموافق 14 أيلول 2025، رسالة الماجستير الموسومة ” استجابة البكتريا اللانموذجية الموجبة الكرام والمعزولة من المصادر السريرية في الموصل / العراق”، للطالب عامر رجب محمود من فرع الأحياء المجهرية.
شهدت المناقشة حضور السيدة عميد كلية العلوم الأستاذ الدكتورة هيام عادل إبراهيم ومعاونيها للشؤون العلمية والإدارية، والسيد رئيس القسم، وعدد من تدريسيي الكلية.
تناولت الدراسة التحري والعزل والتشخيص للبكتريا اللانموذجية الموجبة لصبغة كرام من العينات السريرية في مدينة الموصل، باستخدام الفحوصات الكيموحيوية والتقنيات الجزيئية. كما تضمنت تصنيع وسط محلي محوّر لأول مرة، واستعمال كريات الدم المعلبة (Packed RBCs) التي ساعدت في إظهار مناطق تحلل نوع “ألفا”.
ومن أبرز نتائج البحث:
- تشخيص عزلات بكتريا Facklamia hominis باستخدام الخريطة الحرارية، وإنشاء شجرة تطورية ومقارنتها بالعزلات العالمية.
- اعتماد جهاز Vitek-2 في التشخيص ومطابقة نتائجه مع النتائج الجزيئية.
- اختبار حساسية العزلات للمضادات الحيوية والمستخلصات النباتية (قشور الرمان، العكبر، القرفة، المرة، بذور العنب)، وتقييم فعاليتها مقارنة بالمضادات الحيوية.
ويُعد هذا البحث أول اكتشاف وتسجيل لهذه البكتريا من عينات سريرية في العراق، حيث تم اعتماد السلالات المكتشفة رسميًا ضمن قاعدة بيانات المركز الوطني لمعلومات التقانات الحياتية (NCBI) تحت أرقام الوصول:
PV719694.1، PV719695.1، PV719696.1، PV719697.1.
كما انسجمت محاور هذه الدراسة مع أهداف التنمية المستدامة من خلال:
- الهدف الثالث (الصحة الجيدة والرفاه) .
- الهدف التاسع (الصناعة والابتكار والهياكل الأساسية) .
- الهدف الخامس عشر (الحياة في البر) .
ترأس لجنة المناقشة الأستاذ الدكتور إسراء غانم حازم ، وعضوية كل من:
الأستاذ المساعد الدكتور أنمار أحمد داؤود .
الأستاذ المساعد أنغام جبار علوان .
وبإشراف وعضوية الأستاذ المتمرس الدكتور باسمة أحمد عبدالله.
تمنياتنا لطلبتنا الأعزاء دوام الموفقية والنجاح في مسيرتهم العلمية والبحثية.
شعبة الاعلام والاتصال الحكومي
الاحد 14 ايلول 2025